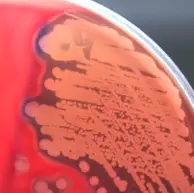
圖片

109年:(醫檢)微生(2)
承上題【圖示細菌在血液培養皿中的溶血現象是屬於: 】,下列何種細菌不會在 BAP 上產生此型態的溶血?
AStreptococcus pyogenes
BStaphylococcus aureus
CStreptococcus dysgalactiae subsp. equisimilis
DStreptococcus mitis
詳細解析
本題觀念:
本題承接上題,上題圖示血液培養皿(blood agar plate, BAP)中的溶血現象為β溶血(beta-hemolysis),即細菌菌落周圍呈現完全透明清澈的溶血環,代表紅血球被完全溶解。本題考查哪一種細菌不會在 BAP 上產生 β 溶血。
影像分析:
圖片顯示一個紅色血液培養皿(BAP),可見菌落周圍有明顯的透明清澈溶血環,此為典型的 β 溶血(完全溶血, complete hemolysis) 表現。β 溶血的特徵:菌落周圍紅血球被完全破壞,形成肉眼可見的透明(無色)清澈暈環。這與 α 溶血(部分溶血,呈現綠色暈環)及 γ 溶血(無溶血)有明顯區別。
選項分析
(A) Streptococcus pyogenes S. pyogenes(A 群鏈球菌, Group A Streptococcus)是最典型的 β 溶血細菌。在 BAP 上,S. pyogenes 形成灰白色小菌落,周圍有明顯的 β 溶血環,溶血環直徑通常為菌落直徑的 2–4 倍。其溶血素包括 streptolysin S(需氧,表面型)和 streptolysin O(厭氧,深層型)。此菌會產生 β 溶血,不符合題目所問。
(B) Staphylococcus aureus S. aureus(金黃色葡萄球菌)在
...(解析預覽)...

升級 VIP 解鎖圖文解析